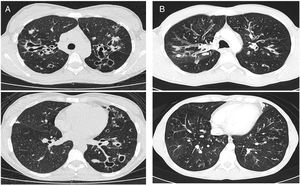
CT images comparison between male and female with the same FEV1: (A) 35 year-old female. Severe bronchiectasis on upper lobes (scored 3), mild peribronchial thickening (scored 1), peripheral mucus plugs are present on upper lobes (scored 2), sacculations are present on left lower lobe. Sparing of distal peripheral zones is detected. Total Bhalla score: 10. FEV1 60%. (B) 40 year-old male. Moderate bronchiectasis (scored 2), mild peribronchial thickening (scored 1), mucus plugging (scored 2) was present on upper lobes. Sparing of distal peripheral zones is detected. Total Bhalla score: 17. FEV1 60%.

The survival of women with cystic fibrosis (CF) is lower than that of men by approximately 5 years. While various factors have been put forward to account for this discrepancy, no specific reasons have been established. Our hypothesis was that anatomical-structural involvement is more pronounced in women with CF than in men and that this is reflected in thoracic HRCT findings.
Material and methodsWe performed a prospective multicentre study, in which adult patients were consecutively included over 18 months. Chest HRCT was performed, and findings were scored by 2 thoracic radiologists using the modified Bhalla system. We also studied respiratory function, applied the CFQR 14+ questionnaire, and collected clinical variables.
ResultsOf the 360 patients followed up in the participating units, 160 were eventually included. Mean age was 28 years, and 47.5% were women. The mean±SD global score on the modified Bhalla score was 13.7±3.8 in women and 15.2±3.8 in men (p=0.024). The highest scores were observed for sacculations, bronchial generations, and air trapping in women. Women had lower BMI, %FEV1, %FVC, and %DLCO. Similarly, the results for the respiratory domain in CFQR 14+ were worse in women, who also had more annual exacerbations.
ConclusionsThis is the first study to provide evidence of the implication of sex differences in HRCT findings in patients with CF. Women with CF present a more severe form of the disease that results in more frequent exacerbations, poorer functional and nutritional outcomes, deterioration of quality of life, and greater structural damage.
La supervivencia de las mujeres con fibrosis quística (FQ) es menor que la de los varones, en aproximadamente 5 años. Si bien se han presentado varios factores para explicar esta discrepancia, no se han establecido razones específicas. Nuestra hipótesis fue que el compromiso anatómico-estructural es más pronunciado en las mujeres con FQ que en los varones, y que esto se refleja en los hallazgos de la TCAR torácica.
Materiales y métodosRealizamos un estudio prospectivo multicéntrico, en el que los pacientes adultos se fueron incluyendo consecutivamente durante 18 meses. Se realizó un TCAR de tórax, y 2 radiólogos torácicos evaluaron los hallazgos utilizando la escala de Bhalla modificada. También estudiamos la función respiratoria, aplicamos el cuestionario CFQR 14+ y recogimos ciertas variables clínicas.
ResultadosDe los 360 pacientes en seguimiento en las unidades participantes, finalmente se incluyeron 160. La edad media fue de 28 años, y el 47,5% eran mujeres. La puntuación global media±DE en la escala de Bhalla modificada fue de 13,7±3,8 en mujeres y de 15,2±3,8 en varones (p=0,024). Las puntuaciones más altas se observaron para las saculaciones o abscesos, las generaciones bronquiales y el atrapamiento de aire en mujeres. Las mujeres tenían un IMC, % FEV1, % FVC y % DLCO más bajos. Del mismo modo, los resultados para el dominio respiratorio en el CFQR 14+ fueron peores en las mujeres, que también tenían más exacerbaciones anuales.
ConclusionesEste es el primer estudio que proporciona evidencia de la implicación de las diferencias de sexo en los hallazgos de la TCAR en pacientes con FQ. Las mujeres con FQ presentan una forma más grave de la enfermedad que resulta en exacerbaciones más frecuentes, peores resultados funcionales y nutricionales, deterioro de la calidad de vida y mayor daño estructural.
Cystic fibrosis (CF) is an autosomal recessive disease resulting from malfunction of the protein CFTR, a transmembrane protein that leads to dehydration and viscous secretions in the lumina of affected organs. The main causes of morbidity and mortality are respiratory involvement, progressive pathogenic infection by specific bacteria—especially Pseudomonas aeruginosa—and the host inflammatory response, which results in poorer pulmonary function and altered pulmonary architecture.1
Pulmonary exacerbations (PEx) contribute to progressive respiratory impairment, reduced quality of life (physical and psychosocial), and increased morbidity. The annual number of PEx has a considerable negative impact on the survival of patients with CF.2,3
Pulmonary function tests (PFTs) are the approach of choice for monitoring respiratory involvement, although high-resolution computed tomography (HRCT) is able to reveal early and focal alterations that have little effect on the results of PFTs.4 For example, slices acquired in expiration enable detection of air trapping stemming from early involvement of the small airway, whereas images acquired in inspiration reveal bronchiectasis. This irreversible and progressive change in pulmonary architecture is an independent risk factor for exacerbations. It also reduces quality of life and increases mortality.5 The modified Bhalla scoring system and the more complex Brody II scale have been the object of study for the monitoring and quantification of visible structural changes in the lung.6,7
The many factors involved in the poor prognosis of CF include more severe genotype, low body mass index (BMI), early auscultation of crackles, acquisition of certain bacteria, low expiratory volume in the first second (FEV1), frequent hospitalizations, diabetes, early diagnosis, environmental and socioeconomic factors, and female sex.8
According to various registries, survival in women with CF is lower than survival in men by around 5 years.9,10 Associated factors include poorer nutritional status, early acquisition of P. aeruginosa infection, and conversion to the mucoid phenotype, which leads to an increase in PEx and more marked functional impairment.11,12
While no explanation has been found to account for this difference in survival between men and women with CF, female sex hormones, especially oestrogen, have been blamed. Oestrogen has been reported to compromise pulmonary clearance by decreasing periciliary fluid on the bronchial surface, leading to greater viscosity of respiratory secretions and, consequently, early acquisition of respiratory pathogens.13
No studies to date have analyzed the impact of sex differences on the pulmonary architecture of patients with CF. The aims of this study were to demonstrate—based on thoracic HRCT findings—the increased structural damage and severity of the disease in adult women with CF. We also analyze differences between men and women in clinical features, such as nutritional status, lung function, chronic bronchial infection, respiratory exacerbations, and complications.
Material and methodsWe performed an observational, prospective (1 year), cross-sectional, and multicentre study in a cohort of adult patients (≥18 years) diagnosed with CF.14 The participating centres were University Hospital La Princesa, Hospital de La Paz, and Hospital Ramón y Cajal in Madrid, Central Hospital of Oviedo in Asturias, and University Regional Hospital in Malaga.
The inclusion criteria were confirmed diagnosis of CF, clinical stability in the previous month (i.e., no antibiotic treatment), full understanding of the procedure, and signed informed consent. The study was approved by the local ethics committees.
Participants who met the inclusion criteria and underwent chest HRCT in the recruitment period were included progressively from January 2015 to August 2016.
At the time of inclusion, clinical and demographic variables were collected, and PFTs (spirometry and plethysmography) was assessed, avoiding a time gap between the imaging test (±2–3 weeks). Patients were differentiated by sex (women and men). The variables collected were age (expressed in years, calculated from the date of birth until the date of HRCT), genotype (F508 for homozygotes, F508 for heterozygotes, and other mutations), body mass index (BMI), presence of pancreatic insufficiency (defined as pancreatic enzymes with lower faecal elastase levels [≤200μg/g]), CF-related diabetes with fasting hyperglycaemia (fasting blood glucose >126mg/dl or >200mg/dl at 2h), allergic bronchopulmonary aspergillosis,15 and chronic bronchial infection defined according to the Leeds criteria.16 In addition, chronic treatment was defined as that administered for ≥3 months and included macrolides, aerosol antibiotics (e.g., colistin, tobramycin, and aztreonam), oral corticosteroids, inhaled corticosteroids, ibuprofen, oral antibiotics, aerosol therapy with DNase, hypertonic saline, and physiological saline 0.9%. Complications included the presence of severe haemoptysis (>400–600ml/day or 150ml/h).
At the visit where the HRCT was performed, participants also filled in the Cystic Fibrosis Questionnaire-Revised (CFQR), as validated in Spanish for adolescents and adults with CF (age >14 years) (CFQR 14+).17 This quality of life questionnaire assesses areas such as physical capacity, vitality, perceived health, and respiratory symptoms. Scores vary from 0 to 100 points, with higher scores corresponding to a better perceived quality of life. The scores for each domain are calculated if at least two-thirds of the questions are completed.
PEx were defined as a worsening of baseline symptoms that necessitated additional antibiotic treatment. They were classified as mild-moderate if they required oral antibiotic treatment and severe if treatment was intravenous. PEx from the year before inclusion in the study were also collected. Irrespective of whether they were mild-moderate or severe, PEx and complications were collected in the year following inclusion.
Non-contrast-enhanced examination was performed with a first acquisition obtained in the supine position with sustained end-inspiration (volumetric acquisition). The acquisition parameters were as follows: collimation, 64mm×0.6mm; rotation time, 0.5s; pitch, 1.41; 120kVp; and mean mAs, 120mAs (performed with automatic exposure control). A second acquisition was obtained in the supine position at 3 levels: aortic arch, tracheal carina, and 3cm above the right diaphragm with sustained end-expiration after a prolonged expiration (sequential acquisition). The acquisition parameters were as follows: slice thickness, 1mm; rotation time, 0.5s; 120kVp; mean mAs, 220mAs. The mean dose length product for the whole study was 185mGy/cm. The images were assessed and scored by 2 thoracic radiologists in each participating hospital. We chose the Bhalla system and not the Brody II system because the Bhalla system is easier to use in normal clinical practice and we consider the Brody II system more complex. While MRI and tomosynthesis have been investigated, they are not commonly used and are less available for assessment of patients with CF in clinical practice. CT is used frequently in our daily hospital practice.
The Bhalla score evaluates the severity of bronchiectasis, peribronchial thickening, extension of bronchiectasis (number of pulmonary segments), extension of mucus plugging, sacculations and abscesses, involvement of bronchial generations, number of bullae, emphysema, and collapse/consolidation. Instead of assessing emphysema and its extension, we evaluated the extent of air trapping in the expiratory sections (Table 1). The points in each category vary from 0 to 3. The sum of the score obtained for each item was subtracted from 25 in order to obtain the overall Bhalla score. Different examples of Bhalla scores are shown in Fig. 1.7
Bhalla modified score system.
| 0 | 1 | 2 | 3 | |
|---|---|---|---|---|
| Severity of bronchiectasis | Absent | Mild (Luminal diameter slightly greater than diameter of adjacent blood vessel) | Moderate (Luminal diameter 2–3 greater than diameter of vessel) | Severe (Luminal diameter >3 times greater than diameter of vessel) |
| Thickening | Absent | Mild (Wall thickness equal to diameter of adjacent vessel) | Moderate (Wall thickness up to 2 times the diameter of adjacent vessel) | Severe (Wall thickness >2 times the diameter of adjacent vessel) |
| Extention of bronchiectasis | Absent | 1–5 | 6–9 | >9 |
| Mucous plugging | Absent | 1–5 | 6–9 | >9 |
| Sacculations | Absent | 1–5 | 6–9 | >9 |
| Involvement of bronchial generations | Absent | >4th generation | >5th generation | >6th generation |
| Bullae | Absent | Unilateral (<4) | Bilateral (<4) | >4 |
| Air trapping | Absent | 1–5 | >5 | |
| Atelectasis | Absent | Subsegmental | Segmental/lobar |
Axial CT images of pulmonary window in different patients with CF and different Bhalla scores. Bhalla 23 is an example of a mild disease with mild bronchiectasis while Bhalla 16 presents a moderate disease with mucous plugging and bigger bronchiectasis. Finally, Bhalla 10 shows a severe disease with sacculations, greater thickness wall and higher luminal diameter of bronchiectasis, also with mucous plugging and air trapping.
In relation to the PFTs, the parameters evaluated were forced vital capacity (FVC), forced expiratory volume in 1s (FEV1), FEV1/FVC ratio, diffusion capacity (DLCO), residual volume (RV), total lung capacity (TLC), functional residual capacity (FRC), RV/TLC, and the ratio of inspiratory capacity to total lung capacity (IC/TLC).
Statistical methodologyA univariate descriptive analysis was carried out. Quantitative variables were expressed as mean and standard deviation, and qualitative variables as percentages. The Kolmogorov–Smirnov or Shapiro–Wilk test was performed to study the normality of the sample distribution according to the number of subjects. The t test and the Mann–Whitney test were applied for the bivariate analysis depending on whether the variables were parametric or non-parametric.
SPSS version 22.0 (IBM Corp, Armonk, New York, USA) was used for the statistical analysis. Statistical significance was set at p≤0.05.
ResultsWe included 160 patients from a total of 360 adults with CF. Of these, 84 corresponded to Hospital La Princesa, 25 to University Regional Hospital in Malaga, 23 to Central Hospital of Asturias, 17 to Hospital Ramón y Cajal, and 11 to Hospital La Paz (Fig. 2).
The demographic characteristics of the cohort are shown in Table 2.
Study population.
| Variable / n = 160 patients | TOTAL | GENDER | ||
|---|---|---|---|---|
| (n) percentage/ | Female(n) percentage/ | Male(n) percentage/ | P value | |
| Mean ± SD | Mean ± SD | Mean ± SD | ||
| Age (years), mean±SD | 28±1.9 | 27.84±9.32 | 28.19±9.05 | 0.715 |
| Gender (male) | (76) 47.5% | (84) 52.5% | - | |
| Body mass index (kg/m2), mean±SD | 21.9±3 | 21.29±3.12 | 22.57±2.80 | 0.002 |
| Genotype | ||||
| del F508/del F508 | (44) 27.5% | (19) 25% | (25) 29.8% | 0.652 |
| delF508/other | (74) 46.3% | (38) 50% | (36) 42.9% | |
| other/other | (42) 26.3% | (19) 25% | (23) 27.4% | |
| Diabetes | (38) 23.9% | (18) 23.7% | (20) 24.1% | 0.951 |
| Pancreatic insufficiency | (121) 75.6% | (57) 75% | (64) 76.2% | 0.861 |
| AIRWAY COLONIZATION | ||||
| Staphylococcus aureus | (96) 60% | (45) 59,2% | (51) 60,7% | 0.846 |
| Methicillin-resistant Staphylococcus aureus | (17) 10,6% | (9) 11,8% | (8) 9,5% | 0.635 |
| Pseudomonas aeruginosa | (73) 45,6% | (35) 46,1% | (38) 45,2% | 0.918 |
| Haemophilus influenzae | (26) 18,9% | (16) 24,6% | (10) 13,9% | 0.110 |
| Achromobacter xylosoxidans | (18) 11,2% | (11) 14,5% | (7) 8,3% | 0.220 |
| Stenotrophomonas maltophilia | (16) 10% | (11) 14,5% | (5) 6,0% | 0.073 |
| Proteus mirabilis | (1) 0,6% | (0) 0% | (1) 1,2% | 0.340 |
| Burkholderia cepacia | (12) 7,5% | (4) 5,3% | (8) 9,5% | 0.307 |
| Aspergillus sp. | (41) 25,6% | (25) 32,9% | (16) 19% | 0.045 |
| Candida sp. | (27) 16,8% | (11) 14,5% | (16) 19,0% | 0.440 |
| Non tuberculosis micobacterias | (96) 60% | (45) 59,2% | (51) 60,7% | 0.846 |
| EXACERBATIONS, mean±SD | ||||
| Exacerbation during the previous year | 2.2±1.7 | 2.51±1.88 | 1.88±1.60 | 0.030 |
| Cycles of oral antibiotic during the previous year | 1.7±1.4 | 1.83±1.52 | 1.54±1.37 | 0.270 |
| Cycles of intravenous antibiotic during the previous year | 0.5±1.0 | 0.61±1.13 | 0.40±0.87 | 0.234 |
| Exacerbation during follow-up | 2.5±2.0 | 3.08±2.34 | 2.05±1.58 | 0.004 |
| Cycles of oral antibiotic during follow-up | 2.0±1.7 | 2.48±2.06 | 1.62±1.28 | 0.008 |
| Cycles of intravenous antibiotic during follow-up | 0.5±0.9 | 0.60±1.12 | 0.39±0.81 | 0.352 |
| TREATMENTS | ||||
| Long-term treatment (without azithromycin) | (138) 86.2% | (68) 89.5% | (70) 83.3% | 0.260 |
| Macrolides | (83) 52.5% | (44) 58.7% | (39) 47.0% | 0.142 |
| Aerosolized antibiotics | (124) 78.5% | (58) 77.3% | (66) 79.5% | 0.564 |
| Oral corticosteroids | (9) 5.6% | (4) 5.3% | (5) 6.0% | 0.850 |
| Ibuprofen | (6) 3.8% | (4) 5.3% | (2) 2.4% | 0.337 |
| DNase | (52) 33.1% | (27) 36% | (25) 30.5% | 0.464 |
| Oral antibiotics | (40) 25% | (16) 21.1% | (24) 28.6% | 0.273 |
| Inhaled hypertonic saline | (92) 57.5% | (48) 63.2% | (44) 52.4% | 0.168 |
| Inhaled physiological saline | (5) 3.1% | (2) 2.7% | (3) 3.6% | 0.756 |
| PULMONARY COMPLICATIONS, NONINFECTIOUS | ||||
| Allergic bronchopulmonary aspergillosis | (26) 16.2% | (9) 11.8% | (17) 20.2% | 0.151 |
| Massive haemoptysis | (5) 3.3% | (1) 1.3% | (4) 5.1% | 0.187 |
| Pneumothorax | (4) 2.5% | (1) 1.3% | (3) 3.6% | 0.361 |
| Lung transplant | (5) 3.3% | (3) 4.0% | (2) 2.6% | 0.628 |
Analysis of differences by sex revealed that women had poorer nutritional status and their mean BMI was 21.29±3.12kg/m2, while that of men was 22.57±2.80kg/m2 (p=0.002). Chronic bronchial infection due to Burkholderia cepacia was more common in women (32.9% vs. 19% [p=0.045]), with no differences for the remaining pathogens analyzed. PEx were also more common in women, ie, both those detected during the year prior to inclusion and those detected during the subsequent year. The differences were statistically significant (p=0.030 and p=0.004, respectively).
The final result obtained in the modified Bhalla score and in each of the items separately is shown by sex in Table 3. Those for which higher scores were recorded were extension of bronchiectasis, involvement of bronchial generations, and severity of bronchiectasis, thus illustrating practically generalized involvement of the bronchial tree. The modified Bhalla score was 13.70±3.87 points in women and 15.23±3.82 points in men (p=0.024). The items that showed greater involvement in women were sacculations, bronchial generations, and air trapping (Fig. 3).
Modified Bhalla score according to gender.
| Total (n=160)Mean±SD | Gender | p Value | ||
|---|---|---|---|---|
| Female (n=76) | Male (n=84) | |||
| Mean±SD | Mean±SD | |||
| Bhalla | 14.50±3.90 | 13.70±3.87 | 15.23±3.82 | 0.024 |
| Severity | 1.92±0.88 | 2.03±0.93 | 1.83±0.84 | 0.164 |
| Thickening | 1.29±0.73 | 1.35±0.74 | 1.24±0.73 | 0.383 |
| Extension of bronchiectasis | 2.49±0.83 | 2.57±0.79 | 2.41±0.87 | 0.193 |
| Extension of plugging | 1.13±0.88 | 1.21±0.90 | 1.05±0.86 | 0.253 |
| Sacculations | 0.33±0.58 | 0.45±0.70 | 0.22±0.42 | 0.042 |
| Involvement of bronchial generations | 2.04±0.87 | 2.20±0.84 | 1.89±0.89 | 0.023 |
| Bullae | 0.17±0.55 | 0.12±0.40 | 0.21±0.66 | 0.678 |
| Air trapping | 0.81±0.79 | 0.97±0.84 | 0.66±0.72 | 0.018 |
| Atelectasis | 0.41±0.66 | 0.44±0.66 | 0.39±0.66 | 0.531 |
CT images comparison between male and female with the same FEV1: (A) 35 year-old female. Severe bronchiectasis on upper lobes (scored 3), mild peribronchial thickening (scored 1), peripheral mucus plugs are present on upper lobes (scored 2), sacculations are present on left lower lobe. Sparing of distal peripheral zones is detected. Total Bhalla score: 10. FEV1 60%. (B) 40 year-old male. Moderate bronchiectasis (scored 2), mild peribronchial thickening (scored 1), mucus plugging (scored 2) was present on upper lobes. Sparing of distal peripheral zones is detected. Total Bhalla score: 17. FEV1 60%.
As for pulmonary function (Table 4), the participating cohort had moderate obstructive ventilatory abnormalities, as well as pulmonary hyperinflation, with a consequent increase in RV, RV/TLC, and FRC, in addition to a slight decrease in DLCO. A significant reduction in FEV1 and FVC (absolute value and percentage) was observed in women, although this decrease was not reflected in the FEV1/FVC ratio. However, in women, the RV/TLC ratio had values compatible with pulmonary hyperinflation (41.44±11.21). Likewise, a significant decrease in oxygen transfer capacity was observed in women (DLCO <80% in women), but not in men.
Pulmonary function values based on gender.
| Pulmonary function | TotalMean±SD | Gender | p Value | |
|---|---|---|---|---|
| Female | Male | |||
| Mean±SD | Mean±SD | |||
| FVC % | 85.20±20.09 | 81.26±21.0 | 88.77%±18.64 | 0.018 |
| FEV1% | 67.59±22.94 | 62.66±21.52 | 72.05±23.39 | 0.009 |
| FEV1/FVC | 65.79±12.14 | 65.34±12.69 | 66.20±11.69 | 0.658 |
| RV% | 149.51±54.34 | 150.75±47.65 | 148.34±60.29 | 0.786 |
| TLC% | 101.14±18.42 | 101.25±18.28 | 101.04±18.67 | 0.950 |
| FRC% | 121.39±30.15 | 117.33±27.16 | 125.66±32.68 | 0.123 |
| RV/TLC% | 120.56±55.79 | 120.33±56.98 | 120.79±54.96 | 0.952 |
| IC/TLC | 37.19±14.82 | 36.35±17.08 | 38.06±12.14 | 0.171 |
| DLCO% | 79.67±17.87 | 74.08±15.00 | 84.89±18.82 | <0.001 |
Table 5 shows quality of life as perceived by the study patients and calculated using the CFQR. The scores were lower for women in each of the items evaluated, with the only significant differences being in the domains of respiratory symptoms and physical functioning. This reveals worse perceived quality of life.
Quality of life according to gender.
| Quality of life (CFQR 14+) | Total score | Female | Male | p |
|---|---|---|---|---|
| Mean±SD | Mean±SD | |||
| Respiratory symptoms | 63.82±19.52 | 58.32±20.29 | 68.91±17.40 | 0.001 |
| Physical functioning | 71.37±24.23 | 66.13±24.72 | 76.16±22.88 | 0.006 |
| Vitality | 67.11±20.59 | 64.89±21.81 | 69.14±19.31 | 0.232 |
| Health perception | 67.63±24.66 | 65.34±24.84 | 69.75±24.45 | 0.183 |
This is the first study to identify differences in HRCT with the modified Bhalla score in a cohort of adult men and women with CF. The study shows greater radiological involvement, more sacculations, more bronchial generations affected, and more air trapping in women. It also warns how women with CF manifest a more severe form of the disease, experience more PEx, have a lower BMI and poorer pulmonary function, and perceive their quality of life to be poorer than that of men with more respiratory symptoms and a lower level of physical functioning.
The unfavourable evolution of CF in women in terms of survival—lung function, PEx, and microbiological isolates—has received much attention over the years. However, it remains a controversial issue.
Classic CF records, such as the Canadian 1996 record, consisting of 3795 patients,10 identified a 5-year decrease in survival in women. The data showed a poorer nutritional status in this group, which led us to suspect that weight was associated with more marked functional impairment.
Despite the overall increase in survival of CF from 14 to 28 years in the 1990s, we continued to observe lower survival in women (25 years vs. 30 years).18 In a study of more than 20,000 American patients, the factors potentially associated with lower survival included nutritional status, lung function, microbiological isolates, pancreatic insufficiency, age at diagnosis, mode of presentation, and race. However, none of these factors could account for the sex differences observed.19
Similar data were collected in the British CF registry in 2017, in which the average age of survival was 43.1 years in women versus 49.6 years in men (p<0.001).
Various groups have tried to elucidate this discrepancy. An Italian group carried out a study with CF patients aged up to 16 years in order to identify sex-related differences but found none.20 Consequently, it was hypothesized that the differences began after adolescence, which is known to be a period of change associated with frequent lack of adherence in chronic diseases. However, while nonadherence has been corroborated in this stage of life, it has not been shown to differ between males and females.21
Equally interesting findings were reported by Masterson et al,22 who analyzed survival in a retrospective cohort of CF patients and data from the American Registry and assessed the influence of age at diagnosis and sex. The authors concluded that in patients diagnosed during childhood, survival was lower in women. However, when the diagnosis was made in adulthood, survival was much higher in women (72 years vs. 62.8 years).22
A review of 39 studies analysing the factors responsible for the deterioration of FEV1 in persons with CF concluded that pancreatic insufficiency and bronchial infection by P. aeruginosa are the most frequent coincidental findings. Nine of the studies also evaluated the implication of sex in the results obtained, and only 5 revealed more marked deterioration of FEV1 in women. In this review, it seems that the decrease in FEV1 is similar in boys and girls aged up to 13 years, when it drops sharply in girls and continues in parallel from the age of 14.23
In the review by Sanders et al.,24 female sex implied a statistically significant greater risk of not recovering baseline lung function after a severe PEx requiring intravenous antibiotics.
In a cohort of 890 Scandinavian patients, Olesen et al.25 identified differential characteristics in women that pointed to a poorer prognosis, namely, a greater predisposition in the acquisition of P. aeruginosa and B. cepacia and a greater requirement for antibiotic treatments and hospitalizations. The authors also reported a higher proportion of adult males. Based on these data, they defended the need for more aggressive treatment in women. In our series, B. cepacia was the only pathogen for which statistically significant sex differences were observed.
Demko et al.26 also reported earlier acquisition of P. aeruginosa in women (1.7 years) and the change to the mucoid phenotype. This transition is known to be associated with worsening cough, radiological scores, and pulmonary function. These findings were corroborated in 79 of the 180 patients diagnosed based on neonatal screening in Colorado (USA), where the predisposing factors for the transition from P. aeruginosa to the mucoid phenotype were studied. The authors concluded that female sex, homozygous F508del genotype, and previous isolation of Staphylococcus aureus could be involved.27
Cogen et al.8 report controversial results on sex differences in CF. The authors analyzed 946 patients aged ≤12 years (EPIC 2004–2006), none of whom were infected by P. aeruginosa, and proposed possible risk factors for the decline in FEV1 (%). The mean annual decrease in FEV1 was 1.01% (95% CI, 0.85–1.17). The carriers of one or no F508del mutations, as well as those diagnosed prenatally or by screening, experienced less decline than homozygotes. In the multivariate analysis, the factors that most influenced the annual fall in FEV1 were frequent and productive cough, low BMI, ≥1 annual PE, baseline FEV1 ≥115%, positive cultures for sensitive and resistant S. aureus or Stenotrophomonas maltophilia, and female sex. In contrast with the study described above, the authors show that, from childhood, girls are more predisposed to impaired pulmonary function, despite the absence of infection by P. aeruginosa.
Another pathogen to be considered in CF is Aspergillus fumigatus, which has been related to worse pulmonary function and independently associated with hospital admissions.28
Consistent with findings from the abovementioned studies, the variables we identified as being worse in women were BMI, pulmonary function parameters (FEV1, FVC, RV/TLC and DLCO), the number of PEx (especially those treated with oral drugs), and the result for the physical and respiratory domains of CFQR 14+. However, we did not observe a greater presence of infection by P. aeruginosa or S. aureus; only the isolates of B. cepacia were significant in women. Similarly, we found no differences in the usual treatments received or in complications such as allergic bronchopulmonary aspergillosis, massive haemoptysis, and pneumothorax, all of which may have contributed to poorer pulmonary function and greater deterioration in HRCT in women.
Radiological involvement as evidenced on thoracic CT has not previously been differentiated by sex. In this study, we found the most marked involvement to be in sacculations, affected bronchial generations, and air trapping. This impairment goes hand in hand with that of functional parameters and quality of life.29
LimitationsThe main limitations of this study are that it is cross-sectional and prospective with only 1 year of follow-up based on a limited number of patients. Consequently, our data must be interpreted with caution. However, it should be noted that less commonly recorded parameters (Bhalla, DLCO) were rigorously assessed.
Another limitation is that some data were not collected, such as age at diagnosis of the disease or acquisition of P. aeruginosa, adherence, physical activity, and respiratory physiotherapy, which could have been relevant if our objective had been to identify factors predisposing to a poorer outcome of CF in women.
ConclusionsThis is the first study to conclude that radiological involvement (sacculations, affected bronchial generations, and greater air trapping) is more severe in adult women with CF than in men of a similar age. Likewise, women manifest a more severe form of the disease, with a higher number of exacerbations and more marked deterioration in pulmonary function, nutritional status, and quality of life.
Our data reinforce the need for more intensive treatments in women with CF and closer follow-up. We must also emphasize the importance of correct adherence to therapy in order to prevent disease progression and PEx in this group and thus try to reverse the worst prognosis.
FundingThis study was funded by “Beca ayuda a la investigación SEPAR”.
Conflict of interestNone.